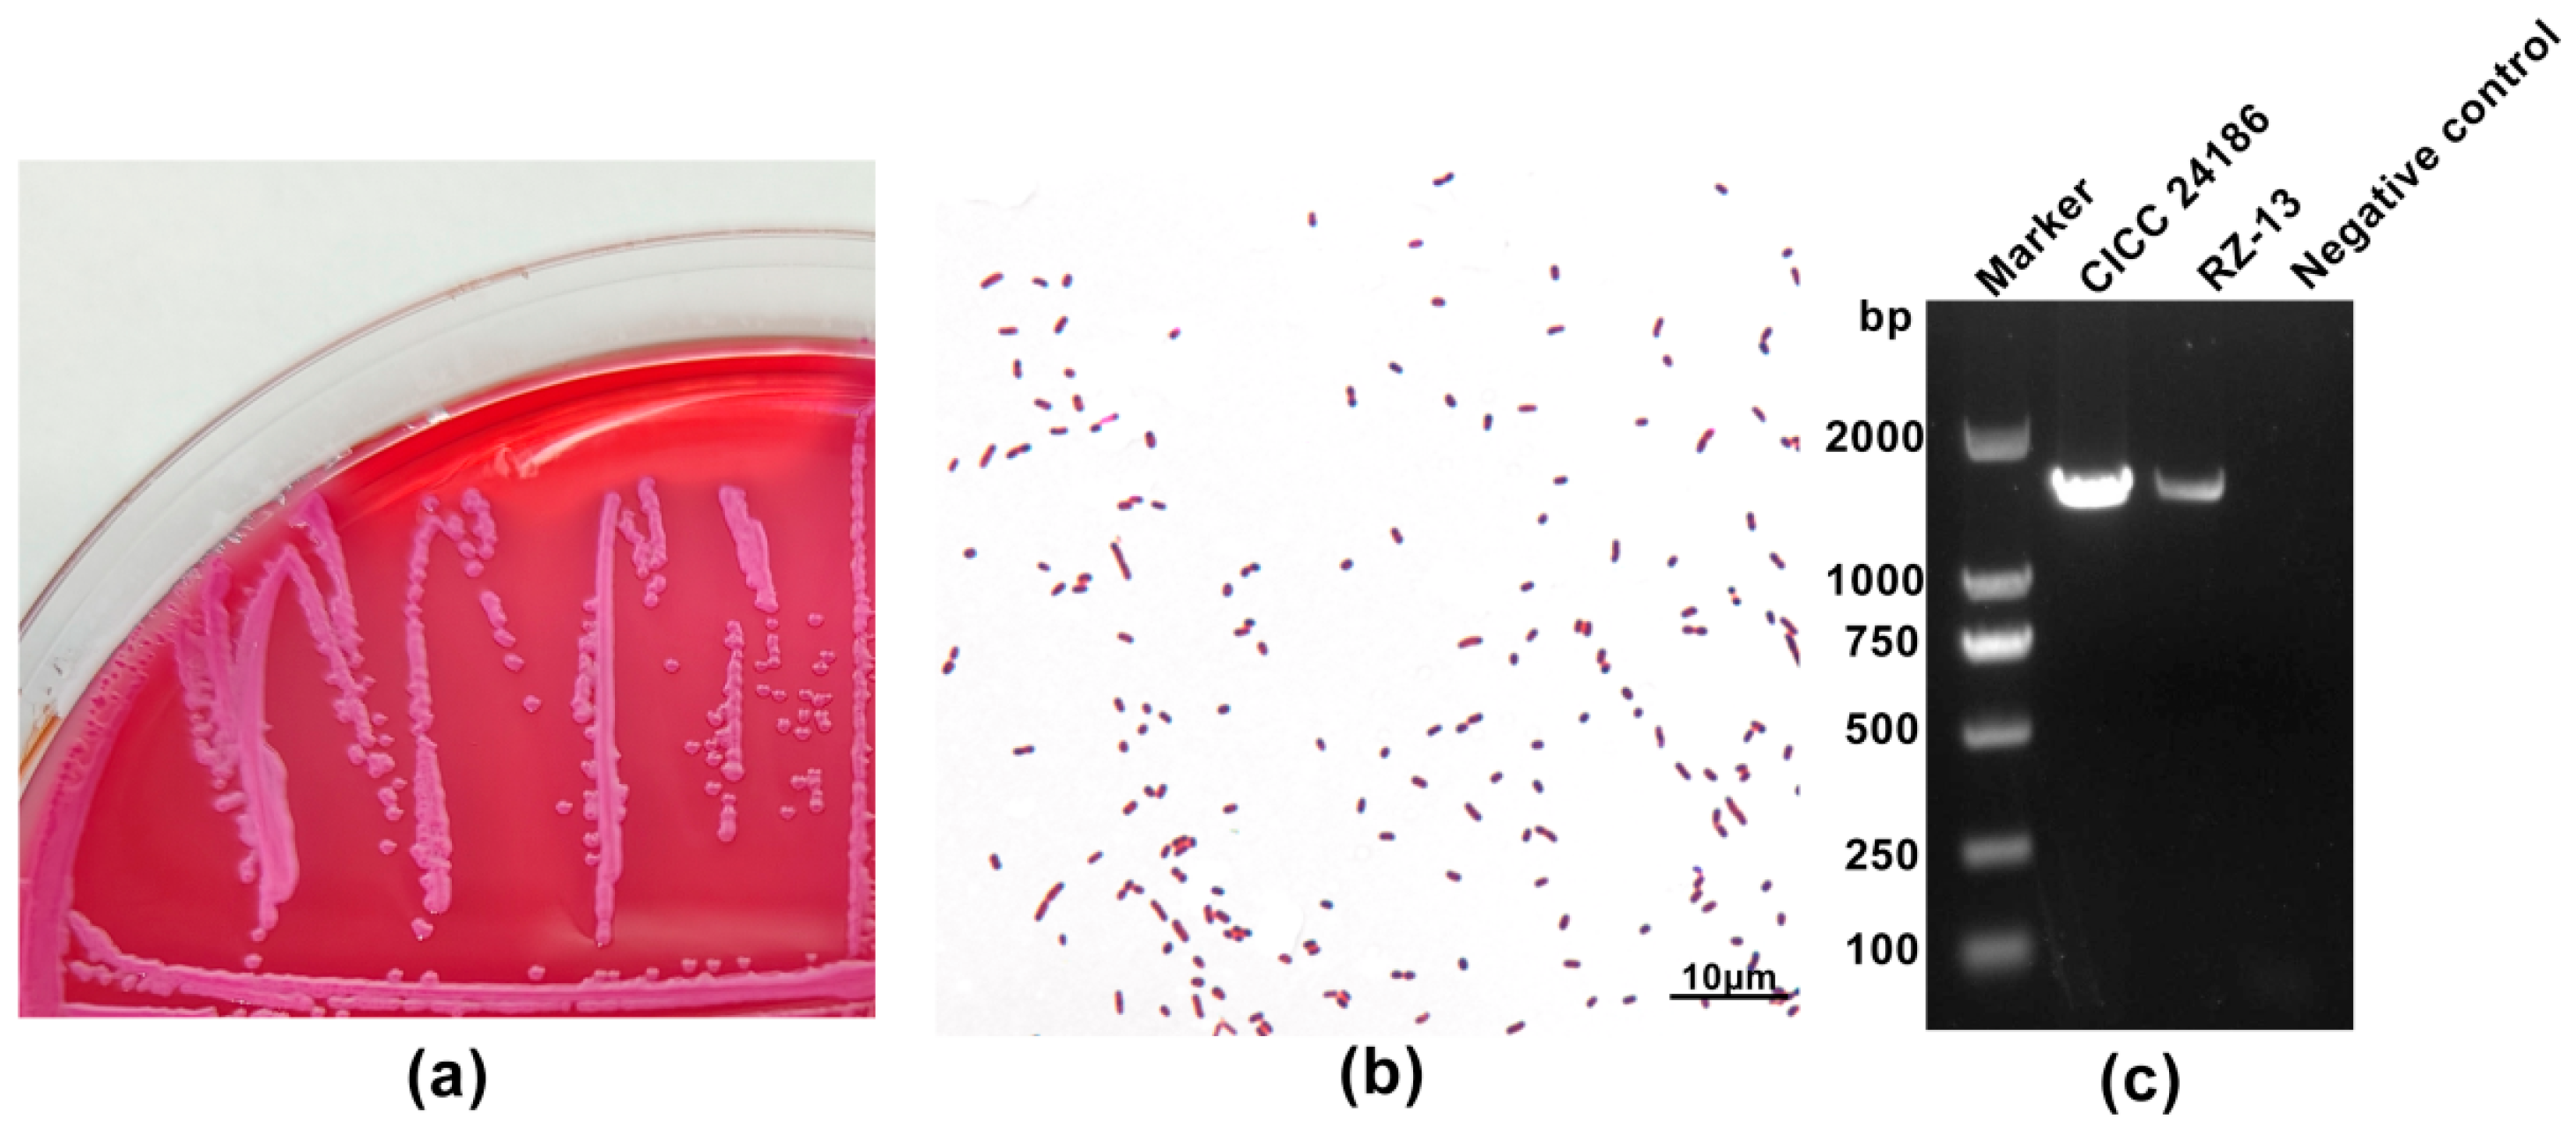

Multidrug-Resistant Extraintestinal Pathogenic Escherichia coli Exhibits High Virulence in Calf Herds: A Case Report
Abstract
1. Introduction
2. Case Description
3. Materials and Methods
3.1. Sample Collection and Identification of E. coli
3.2. Antibiotic Susceptibility Testing
3.3. Experimental Infection of Kunming Mice
3.4. Whole-Genome Sequencing (WGS) and Comprehensive Analysis
3.5. Statistical Analysis
4. Results
4.1. Molecular and Phenotypic Characteristics of the RZ-13 Strain
4.2. Antibiotic Resistance of RZ-13 Strain
4.3. Analysis of Pathogenicity and Pathological Characteristics of RZ-13 Strain Infection in Mice
4.4. Comprehensive Bioinformatics Analysis of RZ-13 Strain
5. Discussion
6. Conclusions
Supplementary Materials
Author Contributions
Funding
Institutional Review Board Statement
Conflicts of Interest
References
- Foster, D.M.; Smith, G.W. Pathophysiology of diarrhea in calves. Vet. Clin. N. Am. Food Anim. Pract. 2009, 25, 13–36. [Google Scholar] [CrossRef] [PubMed]
- Garcia, J.; Pempek, J.; Hengy, M.; Hinds, A.; Diaz-Campos, D.; Habing, G. Prevalence and predictors of bacteremia in dairy calves with diarrhea. J. Dairy Sci. 2022, 105, 807–817. [Google Scholar] [CrossRef] [PubMed]
- Cho, Y.I.; Yoon, K.J. An overview of calf diarrhea—Infectious etiology, diagnosis, and intervention. J. Vet. Sci. 2014, 15, 1–17. [Google Scholar] [CrossRef] [PubMed]
- Arowska, J.; Futoma-Koloch, B.; Jama-Kmiecik, A.; Frej-Madrzak, M.; Ksiazczyk, M.; Bugla-Ploskonska, G.; Choroszy-Krol, I. Virulence factors, prevalence and potential transmission of extraintestinal pathogenic Escherichia coli isolated from different sources: Recent reports. Gut Pathog. 2019, 21, 10. [Google Scholar] [CrossRef]
- Li, X.; Hu, H.; Zhu, Y.; Wang, T.; Lu, Y.; Wang, X.; Peng, Z.; Sun, M.; Chen, H.; Zheng, J.; et al. Population structure and antibiotic resistance of swine extraintestinal pathogenic Escherichia coli from China. Nat. Commun. 2024, 15, 5811. [Google Scholar] [CrossRef]
- Karwowska, E. Antibiotic Resistance in the Farming Environment. Appl. Sci. 2024, 14, 5776. [Google Scholar] [CrossRef]
- Li, H.L.; Zhang, L. Molecular Mechanisms of Antibiotic Resistance and Antibacterial Strategies. Chin. J. Biochem. Mol. Biol. 2024, 40, 759–769. (In Chinese) [Google Scholar] [CrossRef]
- Sabino, Y.N.V.; Santana, M.F.; Oyama, L.B.; Santos, F.G.; Moreira, A.J.S.; Huws, S.A.; Mantovani, H.C. Characterization of antibiotic resistance genes in the species of the rumen microbiota. Nat. Commun. 2019, 10, 5252. [Google Scholar] [CrossRef]
- Nguyet, L.T.Y.; Keeratikunakorn, K.; Kaeoket, K.; Ngamwongsatit, N. Antibiotic resistant Escherichia coli from diarrheic piglets from pig farms in Thailand that harbor colistin-resistant mcr genes. Sci. Rep. 2022, 12, 9083. [Google Scholar] [CrossRef]
- Riley, D.S.; Barber, M.S.; Kienle, G.S.; Aronson, J.K.; von Schoen-Angerer, T.; Tugwell, P.; Kiene, H.; Helfand, M.; Altman, D.G.; Sox, H.; et al. CARE guidelines for case reports: Explanation and elaboration document. J. Clin. Epidemiol. 2017, 89, 218–235. [Google Scholar] [CrossRef]
- Vrenna, G.; Agosta, M.; Fox, V.; Rossitto, M.; Cortazzo, V.; Raimondi, S.; Lucignano, B.; Onori, M.; Mancinelli, L.; Pereyra Boza, M.D.C.; et al. Integrating Diagnostic Approaches in Infant Bacterial Meningitis Caused by a Non-K1 Escherichia coli: A Case Report. Antibiotics 2024, 13, 1144. [Google Scholar] [CrossRef] [PubMed]
- Caballero, M.; Rivera, I.; Jara, L.M.; Ulloa-Stanojlovic, F.M.; Shiva, C. Isolation and molecular identification of potentially pathogenic Escherichia coli and Campylobacter jejuni in feral pigeons from an urban area in the city of lima, Peru. Rev. Inst. Med. Trop. Sao Paulo 2015, 57, 393–396. [Google Scholar] [CrossRef] [PubMed]
- GB 4789.6-2016; National Standard for Food Safety Food Microbiological Testing for Diarrheal Escherichia coli. National Health and Family Planning Commission of the People’s Republic of China, China Food and Drug Administration: Beijing, China, 2016.
- Camacho, C.; Coulouris, G.; Avagyan, V.; Ma, N.; Papadopoulos, J.; Bealer, K.; Madden, T.L. BLAST+: Architecture and applications. BMC Bioinform. 2009, 10, 421. [Google Scholar] [CrossRef] [PubMed]
- Jønsson, R.; Struve, C.; Boisen, N.; Mateiu, R.V.; Santiago, A.E.; Jenssen, H.; Nataro, J.P.; Krogfelt, K.A. Novel aggregative adherence fimbria variant of enteroaggregative Escherichia coli. Infect. Immun. 2015, 83, 1396–1405. [Google Scholar] [CrossRef]
- Hackel, M.A.; Tsuji, M.; Yamano, Y.; Echols, R.; Karlowsky, J.A.; Sahm, D.F. Reproducibility of broth microdilution MICs for the novel siderophore cephalosporin, cefiderocol, determined using iron-depleted cation-adjusted Mueller-Hinton broth. Diagn. Microbiol. Infect. Dis. 2019, 94, 321–325. [Google Scholar] [CrossRef]
- CLSI Standard M02; Performance Standards for Antimicrobial Disk Susceptibility Tests, 14th ed. Clinical and Laboratory Standards Institute: Wayne, PA, USA, 2024.
- CLSI Quick Guide M02-Ed14-QG; CLSI. M02. Disk Diffusion Reading Guide, 2nd ed. Clinical and Laboratory Standards Institute: Wayne, PA, USA, 2024.
- Tamma, P.D.; Heil, E.L.; Justo, J.A.; Mathers, A.J.; Satlin, M.J.; Bonomo, R.A. Infectious Diseases Society of America 2024 Guidance on the Treatment of Antimicrobial-Resistant Gram-Negative Infections. Clin. Infect. Dis. 2024, ciae403. [Google Scholar] [CrossRef]
- Perrott, J.; Mabasa, V.H.; Ensom, M.H.H. Comparing outcomes of meropenem administration strategies based on pharmacokinetic and pharmacodynamic principles: A qualitative systematic review. Ann. Pharmacother. 2010, 44, 557–564. [Google Scholar] [CrossRef]
- Cirillo, I.; Vaccaro, N.; Turner, K.; Solanki, B.; Natarajan, J.; Redman, R. Pharmacokinetics, safety, and tolerability of doripenem after 0.5-, 1-, and 4-hour infusions in healthy volunteers. J. Clin. Pharmacol. 2009, 49, 798–806. [Google Scholar] [CrossRef]
- Sakka, S.G.; Glauner, A.K.; Bulitta, J.B.; Kinzig-Schippers, M.; Pfister, W.; Drusano, G.L.; Sörgel, F. Population pharmacokinetics and pharmacodynamics of continuous versus short-term infusion of imipenem-cilastatin in critically ill patients in a randomized, controlled trial. Antimicrob. Agents Chemother. 2007, 51, 3304–3310. [Google Scholar] [CrossRef]
- Peleg, A.Y.; Hooper, D.C. Hospital-acquired infections due to gram-negative bacteria. N. Engl. J. Med. 2010, 362, 1804–1813. [Google Scholar] [CrossRef]
- Tsuji, B.T.; Pogue, J.M.; Zavascki, A.P.; Paul, M.; Daikos, G.L.; Forrest, A.; Giacobbe, D.R.; Viscoli, C.; Giamarellou, H.; Karaiskos, I.; et al. International consensus guidelines for the optimal use of the polymyxins: Endorsed by the American College of Clinical Pharmacy (ACCP), European Society of Clinical Microbiology and Infectious Diseases (ESCMID), Infectious Diseases Society of America (IDSA), International Society for Anti-Infective Pharmacology (ISAP), Society of Critical Care Medicine (SCCM), and Society of Infectious Diseases Pharmacists (SIDP). Pharmacotherapy 2019, 39, 10–39. [Google Scholar] [CrossRef] [PubMed]
- Long, X.Q.; Zhao, W.X.; Li, X.Z.; Hu, W.J.; Chen, Z.L.; Xing, J.K.; Wang, Z.; Zhao, L.; Sao, Y.B.; Luo, Y. Isolation and identification of a pathogenic Escherichia coli strain from bovine milk and the antibacterial effect of pomegranate peel aqueous extract. Chin. J. Anim. Husb. 2025. (In Chinese) [Google Scholar] [CrossRef]
- Larsen, M.V.; Cosentino, S.; Rasmussen, S.; Friis, C.; Hasman, H.; Marvig, R.L.; Jelsbak, L.; Sicheritz-Pontén, T.; Ussery, D.W.; Aarestrup, F.M.; et al. Multilocus sequence typing of total-genome-sequenced bacteria. J. Clin. Microbiol. 2012, 50, 1355–1361. [Google Scholar] [CrossRef]
- Bartual, S.G.; Seifert, H.; Hippler, C.; Luzon, M.A.; Wisplinghoff, H.; Rodríguez-Valera, F. Development of a multilocus sequence typing scheme for characterization of clinical isolates of Acinetobacter baumannii. J. Clin. Microbiol. 2005, 43, 4382–4390. [Google Scholar] [CrossRef]
- Griffiths, D.; Fawley, W.; Kachrimanidou, M.; Bowden, R.; Crook, D.W.; Fung, R.; Golubchik, T.; Harding, R.M.; Jeffery, K.J.; Jolley, K.A.; et al. Multilocus sequence typing of Clostridium difficile. J. Clin. Microbiol. 2010, 48, 770–778. [Google Scholar] [CrossRef]
- Lemee, L.; Dhalluin, A.; Pestel-Caron, M.; Lemeland, J.F.; Pons, J.L. Multilocus sequence typing analysis of human and animal Clostridium difficile isolates of various toxigenic types. J. Clin. Microbiol. 2004, 42, 2609–2617. [Google Scholar] [CrossRef]
- Wirth, T.; Falush, D.; Lan, R.; Colles, F.; Mensa, P.; Wieler, L.H.; Karch, H.; Reeves, P.R.; Maiden, M.C.; Ochman, H.; et al. Sex and virulence in Escherichia coli: An evolutionary perspective. Mol. Microbiol. 2006, 60, 1136–1151. [Google Scholar] [CrossRef]
- Jaureguy, F.; Landraud, L.; Passet, V.; Diancourt, L.; Frapy, E.; Guigon, G.; Carbonnelle, E.; Lortholary, O.; Clermont, O.; Denamur, E.; et al. Phylogenetic and genomic diversity of human bacteremic Escherichia coli strains. BMC Genom. 2008, 9, 560. [Google Scholar] [CrossRef]
- Joensen, K.G.; Tetzschner, A.M.; Iguchi, A.; Aarestrup, F.M.; Scheutz, F. Rapid and Easy In Silico Serotyping of Escherichia coli Isolates by Use of Whole-Genome Sequencing Data. J. Clin. Microbiol. 2015, 53, 2410–2426. [Google Scholar] [CrossRef]
- Brandis, G.; Gockel, J.; Garoff, L.; Guy, L.; Hughes, D. Expression of the qepA1 gene is induced under antibiotic exposure. J. Antimicrob. Chemother. 2021, 76, 1433–1440. [Google Scholar] [CrossRef]
- Sköld, O. Resistance to trimethoprim and sulfonamides. Vet. Res. 2001, 32, 261–273. [Google Scholar] [CrossRef] [PubMed]
- Mukhopadhyay, R.; Rosen, B.P.; Phung, L.T.; Silver, S. Microbial arsenic: From geocycles to genes and enzymes. FEMS Microbiol. Rev. 2002, 26, 311–325. [Google Scholar] [CrossRef] [PubMed]
- Rosen, B.P. Resistance mechanisms to arsenicals and antimonials. J. Basic. Clin. Physiol. Pharmacol. 1995, 6, 251–263. [Google Scholar] [CrossRef]
- Du, D.; Wang-Kan, X.; Neuberger, A.; van Veen, H.W.; Pos, K.M.; Piddock, L.J.V.; Luisi, B.F. Multidrug efflux pumps: Structure, function and regulation. Nat. Rev. Microbiol. 2018, 16, 523–539. [Google Scholar] [CrossRef]
- Gomes, C.; Martínez-Puchol, S.; Palma, N.; Horna, G.; Ruiz-Roldán, L.; Pons, M.J.; Ruiz, J. Macrolide resistance mechanisms in Enterobacteriaceae: Focus on azithromycin. Crit. Rev. Microbiol. 2017, 43, 1–30. [Google Scholar] [CrossRef]
- Galimand, M.; Courvalin, P.; Lambert, T. Plasmid-mediated high-level resistance to aminoglycosides in Enterobacteriaceae due to 16S rRNA methylation. Antimicrob. Agents Chemother. 2003, 47, 2565–2571. [Google Scholar] [CrossRef]
- Chopra, I.; Roberts, M. Tetracycline antibiotics: Mode of action, applications, molecular biology, and epidemiology of bacterial resistance. Microbiol. Mol. Biol. Rev. 2001, 65, 232–260. [Google Scholar] [CrossRef]
- De Angelis, G.; Del Giacomo, P.; Posteraro, B.; Sanguinetti, M.; Tumbarello, M. Molecular Mechanisms, Epidemiology, and Clinical Importance of β-Lactam Resistance in Enterobacteriaceae. Int. J. Mol. Sci. 2020, 21, 5090. [Google Scholar] [CrossRef]
- Walter, E.G.; Taylor, D.E. Plasmid-mediated resistance to tellurite: Expressed and cryptic. Plasmid 1992, 27, 52–64. [Google Scholar] [CrossRef]
- Schwarz, S.; Kehrenberg, C.; Doublet, B.; Cloeckaert, A. Molecular basis of bacterial resistance to chloramphenicol and florfenicol. FEMS Microbiol. Rev. 2004, 28, 519–542. [Google Scholar] [CrossRef]
- Tang, M.J.; He, Z.L.; Pu, W.X. The Research Progress of Acquired 16S rRNA Methyltransferases. Acta Vet. Zootech. Sin. 2021, 52, 2369–2383. [Google Scholar] [CrossRef]
- Krause, K.M.; Serio, A.W.; Kane, T.R.; Connolly, L.E. Aminoglycosides: An Overview. Cold Spring Harb. Perspect. Med. 2016, 6, a027029. [Google Scholar] [CrossRef] [PubMed]
- Miranda, A.; Ávila, B.; Díaz, P.; Rivas, L.; Bravo, K.; Astudillo, J.; Bueno, C.; Ulloa, M.T.; Hermosilla, G.; Del Canto, F.; et al. Emergence of Plasmid-Borne dfrA14 Trimethoprim Resistance Gene in Shigella sonnei. Front. Cell. Infect. Microbiol. 2016, 6, 77. [Google Scholar] [CrossRef] [PubMed]
- Beggs, G.A.; Brennan, R.G.; Arshad, M. MarR family proteins are important regulators of clinically relevant antibiotic resistance. Protein Sci. 2020, 29, 647–653. [Google Scholar] [CrossRef]
- Zhang, H.; Zhao, D.; Quan, J.; Hua, X.; Yu, Y. mcr-1 facilitated selection of high-level colistin-resistant mutants in Escherichia coli. Clin. Microbiol. Infect. 2019, 25, 517.e1–517.e4. [Google Scholar] [CrossRef]
- Bernal-Córdoba, C.; Branco-Lopes, R.; Latorre-Segura, L.; de Barros-Abreu, M.; Fausak, E.D.; Silva-Del-Río, N. Use of antimicrobials in the treatment of calf diarrhea: A systematic review. Anim. Health Res. Rev. 2022, 23, 101–112. [Google Scholar] [CrossRef]
- Weerdenburg, E.; Davies, T.; Morrow, B.; Zomer, A.L.; Hermans, P.; Go, O.; Spiessens, B.; van den Hoven, T.; van Geet, G.; Aitabi, M.; et al. Global Distribution of O Serotypes and Antibiotic Resistance in Extraintestinal Pathogenic Escherichia coli Collected From the Blood of Patients With Bacteremia Across Multiple Surveillance Studies. Clin. Infect. Dis. 2023, 76, e1236–e1243. [Google Scholar] [CrossRef]
- Laohachai, K.N.; Bahadi, R.; Hardo, M.B.; Hardo, P.G.; Kourie, J.I. The role of bacterial and non-bacterial toxins in the induction of changes in membrane transport: Implications for diarrhea. Toxicon 2003, 42, 687–707. [Google Scholar] [CrossRef]
- Croxen, M.A.; Finlay, B.B. Molecular mechanisms of Escherichia coli pathogenicity. Nat. Rev. Microbiol. 2010, 8, 26–38. [Google Scholar] [CrossRef]
- Karbalaei, M.; Esmailpour, M.; Oksenych, V.; Eslami, M. Comprehensive Analysis of blaCTX-M1 Gene Expression Alongside iutA, csgA, and kpsMII Virulence Genes in Septicemic Escherichia coli Using Real-Time PCR. Microorganisms 2025, 13, 95. [Google Scholar] [CrossRef]
- Iyer, M.S.; Abhinand, P.A.; Hemalatha, C.R. Protein interaction studies of curli fimbriae in Escherichia coli biofilms. Bioinformation 2019, 15, 918–921. [Google Scholar] [CrossRef] [PubMed]
- Soria-Bustos, J.; Saldaña-Ahuactzi, Z.; Samadder, P.; Yañez-Santos, J.A.; Laguna, Y.M.; Cedillo-Ramírez, M.L.; Girón, J.A. The Assembly of Flagella in Enteropathogenic Escherichia coli Requires the Presence of a Functional Type III Secretion System. Int. J. Mol. Sci. 2022, 23, 13705. [Google Scholar] [CrossRef] [PubMed]
- Alvarez-Martinez, C.E.; Christie, P.J. Biological diversity of prokaryotic type IV secretion systems. Microbiol. Mol. Biol. Rev. 2009, 73, 775–808. [Google Scholar] [CrossRef] [PubMed]
- Gao, R.; Wang, C.; Han, A.; Tian, Y.; Ren, S.; Lv, W.; Chen, A.; Zhang, J. Emodin Improves Intestinal Health and Immunity through Modulation of Gut Microbiota in Mice Infected by Pathogenic Escherichia coli O1. Animals 2021, 11, 3314. [Google Scholar] [CrossRef]
- Alexyuk, P.; Bogoyavlenskiy, A.; Alexyuk, M.; Akanova, K.; Moldakhanov, Y.; Berezin, V. Isolation and Characterization of Lytic Bacteriophages Active against Clinical Strains of E. coli and Development of a Phage Antimicrobial Cocktail. Viruses 2022, 14, 2381. [Google Scholar] [CrossRef]
- Cui, J.Q.; Liu, W.H.; Zhang, C.; Zou, L.; Ren, H.Y. Genomic characterization of three bacteriophages infecting donkey-derived Escherichia coli. Virus Genes 2023, 59, 752–762. [Google Scholar] [CrossRef]
- Xiao, T.; Zhu, X.; Wang, W.; Jia, X.; Guo, C.; Wang, X.; Hao, Z. A novel lytic bacteriophage against colistin-resistant Escherichia coli isolated from different animals. Virus Res. 2023, 329, 199090. [Google Scholar] [CrossRef]
- Li, W.; Kai, L.; Jiang, Z.; He, H.; Yang, M.; Su, W.; Wang, Y.; Jin, M.; Lu, Z. Bifidobacterium longum, Lactobacillus plantarum and Pediococcus acidilactici Reversed ETEC-Inducing Intestinal Inflammation in Mice. Microorganisms 2022, 10, 2350. [Google Scholar] [CrossRef]
- Li, K.; Yang, M.; Jia, L.; Tian, M.; Du, J.; Wu, Y.; Yuan, L.; Li, L.; Ma, Y. The Prevention Effect of Lactobacillus plantarum 17-5 on Escherichia coli-Induced Mastitis in Mice. Probiotics Antimicrob. Proteins 2023, 15, 1644–1652. [Google Scholar] [CrossRef]

| Category | Antibiotic-Resistant Genes | Function |
|---|---|---|
| Quinolone | qepA1 | Expels fluoroquinolone antibiotics from bacterial cells [33] |
| Sulfonamide | sul2 | A variant that encodes dihydropteric acid synthase, making it less susceptible to sulfonamide antibiotics [34] |
| sul3 | ||
| Arsenic | arsC | Eliminates arsenic from the cell [35] |
| arsR | Regulates the expression of related arsenic tolerance genes [36] | |
| Lincosamide | lnu(F) | Protects ribosomes from the effects of lincoamide antibiotics |
| Efflux | mdtM | Encodes efflux pump proteins that remove a variety of antibiotics from cells [37] |
| acrF | ||
| emrD | ||
| Macrolide | mph(A) | Catalyzes the phosphorylation of macrolide antibiotics, conferring bacterial resistance to macrolides [38] |
| Rifamycin | arr-2 | Encodes adenylate cyclase ribosyltransferase, which reduces antibiotic activity [39] |
| Tetracycline | tet(A) | Codes tetracycline efflux pump [40] |
| Beta-lactam | blaEC | Codes for beta-lactamase, which inactivates antibiotics [41] |
| blaCTX-M-55 | ||
| blaTEM | ||
| Tellurium | terD | Involved in the expulsion or isolation of tellurides [42] |
| terZ | ||
| terW | ||
| Phenicol | floR | Encodes a membrane transporter that excretes amidoalcohol antibiotics [43] |
| Aminoglycoside | rmtB1 | Aminoglycoside antibiotics fail to bind to ribosomes [44,45] |
| aac(3)-IId | Acetylated aminoglycoside antibiotics [44,45] | |
| aadA22 | Adenosine aminoglycoside antibiotics [44,45] | |
| aph(6)-Id | Phosphorylated aminoglycoside antibiotics [44,45] | |
| aph(3′)-Ia | Phosphorylated aminoglycoside antibiotics [44,45] | |
| Trimethoprim | dfrA14 | Synthesizes a variant of dihydrofolate reductase, thereby reducing the sensitivity of sulfonamides to its effects [46] |
| Ferrous-iron efflux pump (FieF) | fieF | Expels iron ions from the cell |
| Multiple antibiotic resistance protein (MarA) | marA | Multiple-antibiotic-resistant proteins [47] |
| Multiple antibiotic resistance protein (MarR) | marR | Regulates the expression of MarA and other drug resistance genes [47] |
Disclaimer/Publisher’s Note: The statements, opinions and data contained in all publications are solely those of the individual author(s) and contributor(s) and not of MDPI and/or the editor(s). MDPI and/or the editor(s) disclaim responsibility for any injury to people or property resulting from any ideas, methods, instructions or products referred to in the content. |
© 2025 by the authors. Licensee MDPI, Basel, Switzerland. This article is an open access article distributed under the terms and conditions of the Creative Commons Attribution (CC BY) license (https://creativecommons.org/licenses/by/4.0/).
Share and Cite
Zhu, D.-D.; Li, X.-R.; Ma, T.-F.; Chen, J.-Q.; Ge, C.-H.; Yang, S.-H.; Zhang, W.; Chen, J.; Zhang, J.-J.; Qi, M.-M.; et al. Multidrug-Resistant Extraintestinal Pathogenic Escherichia coli Exhibits High Virulence in Calf Herds: A Case Report. Microbiol. Res. 2025, 16, 59. https://doi.org/10.3390/microbiolres16030059
Zhu D-D, Li X-R, Ma T-F, Chen J-Q, Ge C-H, Yang S-H, Zhang W, Chen J, Zhang J-J, Qi M-M, et al. Multidrug-Resistant Extraintestinal Pathogenic Escherichia coli Exhibits High Virulence in Calf Herds: A Case Report. Microbiology Research. 2025; 16(3):59. https://doi.org/10.3390/microbiolres16030059
Chicago/Turabian StyleZhu, Di-Di, Xin-Rui Li, Teng-Fei Ma, Jia-Qi Chen, Chuan-Hui Ge, Shao-Hua Yang, Wei Zhang, Jiu Chen, Jia-Jia Zhang, Miao-Miao Qi, and et al. 2025. "Multidrug-Resistant Extraintestinal Pathogenic Escherichia coli Exhibits High Virulence in Calf Herds: A Case Report" Microbiology Research 16, no. 3: 59. https://doi.org/10.3390/microbiolres16030059
APA StyleZhu, D.-D., Li, X.-R., Ma, T.-F., Chen, J.-Q., Ge, C.-H., Yang, S.-H., Zhang, W., Chen, J., Zhang, J.-J., Qi, M.-M., Zhang, L., & Yang, H.-J. (2025). Multidrug-Resistant Extraintestinal Pathogenic Escherichia coli Exhibits High Virulence in Calf Herds: A Case Report. Microbiology Research, 16(3), 59. https://doi.org/10.3390/microbiolres16030059

